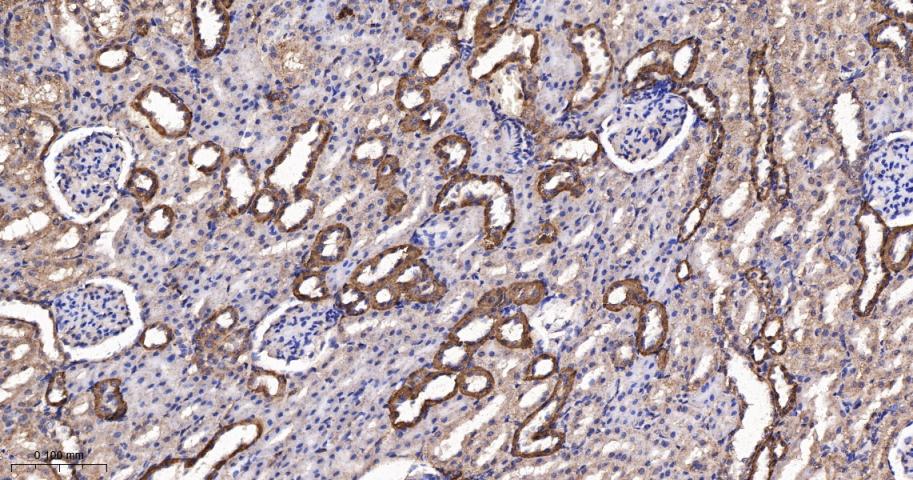
谷草转氨酶2重组兔单抗

谷草转氨酶2重组兔单抗
Rrmab?兔单抗

货号:bsm-62369R
产品详情
相关标记
相关产品
相关文献
常见问题
概述
产品编号
bsm-62369R
产品类型
重组兔单抗
英文名称
GOT2 Recombinant Rabbit mAb
中文名称
谷草转氨酶2重组兔单抗
英文别名
DEE82; KAT4; KATIV; KYAT4; mitAAT; FABP-pm; Got-2; mAspAT; ASPATA; mAAT; AATM_HUMAN; GOT2; Fatty acid-binding protein (FABP-1); Glutamate oxaloacetate transaminase 2; Kynurenine aminotransferase 4; Kynurenine aminotransferase IV; Kynurenine--oxoglutarate transaminase 4; Kynurenine--oxoglutarate transaminase IV; Plasma membrane-associated fatty acid-binding protein (FABPpm); Transaminase A; 2.6.1.1; 2.6.1.7; AATM_MOUSE; AATM_RAT;
抗体来源
Rabbit
免疫原
A synthesized peptide derived from human GOT2: 17-72
亚型
IgG
性状
Liquid
纯化方法
affinity purified by Protein A
克隆类型
Recombinant
克隆号
6E5
理论分子量
48 kDa
检测分子量
43 kDa
储存液
10mM phosphate buffered saline(pH 7.4) with 150mM sodium chloride, 0.05% BSA, 0.02% Proclin300 and 50% glycerol.
研究领域
SWISS
Gene ID
保存条件
Store at 4℃ for short term. Store at -20℃ for long term. Avoid repeated freeze/thaw cycles.
注意事项
This product as supplied is intended for research use only, not for use in human, therapeutic or diagnostic applications.
数据库链接
背景资料
Catalyzes the irreversible transamination of the L-tryptophan metabolite L-kynurenine to form kynurenic acid (KA). As a member of the malate-aspartate shuttle, it has a key role in the intracellular NAD(H) redox balance. Is important for metabolite exchange between mitochondria and cytosol, and for amino acid metabolism. Facilitates cellular uptake of long-chain free fatty acids.

产品应用
| 应用 | 已检合格种属 | 预测种属 | 推荐稀释比例 |
|---|---|---|---|
| WB | Human, Mouse, Rat | 1:500-2000 | |
| IHC-P | Human, Mouse, Rat | 1:100-500 | |
| IHC-F | Human, Mouse, Rat | 1:100-500 | |
| IF | Human, Mouse, Rat | 1:100-500 | |
| IP | Human, Mouse, Rat | 1:20-50 |
交叉反应
交叉反应: Human, Mouse, Rat
相关产品
暂无相关产品
靶标
基因名
GOT2
蛋白名
Aspartate aminotransferase, mitochondrial
亚基
Homodimer.
亚细胞定位
Mitochondrion matrix. Cell membrane. Note=Exposure to alcohol promotes translocation to the cell membrane.
相似性
Belongs to the class-I pyridoxal-phosphate-dependent aminotransferase family.
功能
Catalyzes the irreversible transamination of the L-tryptophan metabolite L-kynurenine to form kynurenic acid (KA). Plays a key role in amino acid metabolism. Important for metabolite exchange between mitochondria and cytosol. Facilitates cellular uptake of long-chain free fatty acids.
标记抗体
暂无标记数据
同靶标产品
暂无同靶标产品
相关文献
提示: 发表研究结果有使用 bsm-62369R 时请让我们知道,以便我们可以引用参考文章。作为回馈,资料提供者将获得我们送上的小礼品。
暂无相关文献
常见问题
暂无常见问题